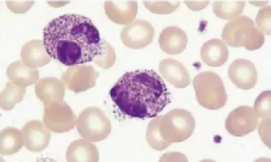

问题
-
患者女 24岁 因左侧关节开口初 闭口末单声弹响来院治疗。临床检查发现患者在开口过程中下颌有偏斜发
-
女 42岁。因反复机会性感染入院 检查发现患者伴发卡波济肉瘤。诊断应首先考虑
-
共用题干患者女 45岁。因急性胆囊炎入院 给予抗感染 对症支持治疗 今晨输液后半小时出现发冷 寒战
-
共用题干患者女 45岁。因急性胆囊炎入院 给予抗感染 对症支持治疗 今晨输液后半小时出现发冷 寒战
-
患者女 58岁。因慢性胆囊炎急性发作入院治疗 给予抗感染 补液 对症治疗 日输液量l000ml。今
-
患者女 45岁。因急性胆囊炎入院 给予抗感染 对症支持治疗 今晨输液后半小时出现发冷 寒战和发热
冀公网安备 13070302000102号